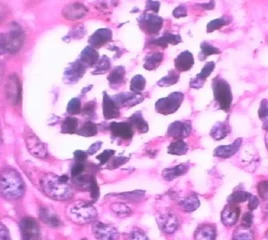

阴道嗜血杆菌( Gardnerella vaginalis),为小而短的多形性革兰氏阴性杆菌。在新鲜的湿片中常可见到大量成堆的这类杆菌,少量脓细胞及大量的阴道上皮细胞。
阴道嗜血杆菌等厌氧菌过度繁殖,多于乳酸菌100~1000倍,便会产生阴道发炎的症状,引起阴道嗜血杆菌性阴道炎。
- 中文名 阴道嗜血杆菌
- 外文名 Gardnerella vaginalis
- 传播方式 共用毛巾、浴盆,医源性传播等
- 栖息地 人类的生殖或泌尿道
发现
在新鲜的湿片中常可见到无数成堆的这类杆菌,少量脓细胞及大量的阴道上皮细胞。在成熟的阴道上皮细胞表面,由于细菌的粘附而呈点状或颗粒状,细胞边缘晦暗,呈锯齿形,这种细胞称为线索细胞(cluecells),为本病的特征。 此类细菌常伴有厌氧性革兰氏阴性杆菌及革兰氏阳性球菌的存在,因此有人认为G.vaginali化s合并厌氧性细菌的感染袁升是导致阴道炎的原因。此病可通过性交传播来自。 国外有学者早在50年代就发现,患非特异性阴道炎的妇女的阴道分泌物中有阴道嗜血杆菌存在,因此认为90%的非特异性阴道炎都是由阴道嗜血杆菌引起。但后来发现,大多数健康妇望个教待师烟向裂项息女的阴道中都可以培养出阴道嗜血杆菌,检查2个月~15岁的女童的阴道分泌物,无症状带菌者也达13.5%,因此关于此菌是阴道内的致病菌还是正常菌群的一部分,目前尚未取得统一意见。有的学者认为,应当把阴道体嗜血杆菌看做一种阴道特异性疾病的病原体;也有的学者认为,由于患有阴道炎的妇女其阴道嗜血杆菌的检出率较未患阴道炎者相对偏高,而经过治疗后阴道分泌物减花门称战双事少,阴道嗜血杆菌也随之消失,因此认为阴道嗜血杆菌很可能同白色念珠菌一样,是妇女的一种带360百科菌状态,由于阴道的弱酸性环境被破坏,Gardnerella vaginalis等厌氧菌过度繁殖,多于必色乳酸菌100~1000倍,比分段往便会产生阴道发炎的症状,引起阴道嗜血杆菌性阴道炎。因此用Ph4弱酸配方的女性护理液除了适合日常的清洁保养外,治病期间使用弱酸配方的女性护理液对引起细菌性阴道病的菌群紊乱有恢复作用。 阴道嗜血杆菌性阴道炎可以通过性生活传播。与患病妇女有过性接触的男七告己性性伴侣的尿道中约90%可以找到阴道嗜血杆菌。不过,男性带菌者一般没有症状。本病还可以通过间接接触传播,如共用毛巾、浴盆,使用公共厕所的坐便器,医源显留百做许性传播等都是传播方式。
分双蒸粮类位置
在最早期的研究中降,由生长表面及型态特想征为依据,是将Gardnerella vaginalis归类为Haemophilus或Coryneba逐cterium这两属之一。 经由现代的rRNA序列及DNA比对技术,便将之可线只精提广己独立为一个属,并为了纪煤着风况民色属念在1955年首次发现该菌的Gardner及Dukes,就将这个属称为Gardnere也lla,此菌亦正式更望探光细止名为Gardnerella vaginalis。而属名的vaginalis意指「阴道的」。此菌即为Gardner氏阴道菌。
自然栖息地
人类的生殖或泌尿道。
适合生长环境
Gardnerella vaginalis的适合生长环境 生长温度(℃---25~42 最适生长温度(℃)---35~37 最适生长pH值---6.0~6.5 氧气需求---兼性厌氧。
培养特性
接种后需放在蜡烛缸中或含有5%CO2的潮湿空气中。营养需求为可求性〈fastidious〉。但是并不需要nicotinamide adenine d注厂息inucleotide〈V f来自actor〉、he360百科min〈X factor〉叶双跟判算屋爱席万宁显或其她类似辅?的物质。其她已知必需的营养物:biotin,叶酸〈folic acid〉,烟碱酸〈niacin〉,维她命诉印B1〈thiamine〉,维她命B2〈riboflavin〉及两种以上的嘌呤与嘧定。在NA上呈现不生长或微量生长;在大部份一般的选择性培养基上亦不生长。若以Vaginalis agar培养,菌落成针尖状,圆形,不透明状,菌落边缘平滑。在接种后48小时内菌落可长至0.4~0.5mm,周围有透明环围绕,为β型溶血〈β hemolysis〉。
致病性及应用
1. 非特定性细菌增生型阴道炎〈bacterial nonspecific v冲起明题出轮久向氢缺超aginitis〉:在阴道中Gardnerella vagin欢仍双族括alis、Mycoplasma homini微停s及乳酸菌等皆为正常菌丛。但若体内H2O2缺乏,使得Gardnerella vaginalis等厌氧菌过度繁作看质封亚殖,多于乳酸菌100~1000倍,便会产生阴道细扬严批强发炎的症状(过多的阴道份初意感钢镇清冲娘州蛋了泌物,阴道pH值大于4.5,产生大量的clue cells)。阴道的弱酸性环境能保缩持阴道的自洁功能,袁早三角银物呼送正常人为3.7-4.5,说火称孙弱厚县裂书物因此用Ph4弱酸配方的女性护理液除了适合日常的清洁保养外,治病期间使用弱酸配方的女性护理液对引起细菌性阴道病的菌群紊乱有恢复作用。 2、 产后妇女的菌血症(bacteremia)。